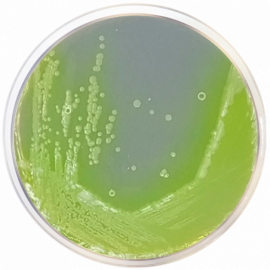

Cetrimide Agar
- Formato: 10 x 90 mm Petri
- Codice: TMB_CETR_P90_10
- Tecnologia: Terreni e test di conferma ISO
- Applicazione: Analisi microbiologiche
- Tag/filtro:
Il terreno Cetrimide Agar è un terreno selettivo utilizzato per l'isolamento ed il conteggio di Pseudomonas aeruginosa in campioni farmaceutici non sterili. La formulazione è conforme ai metodi armonizzati USP/EP/JP.
- Formato: 10 x 90 mm Petri
- Codice: TMB_CETR_P90_10
- Tecnologia: Terreni e test di conferma ISO
- Applicazione: Analisi microbiologiche
- Tag/filtro:

